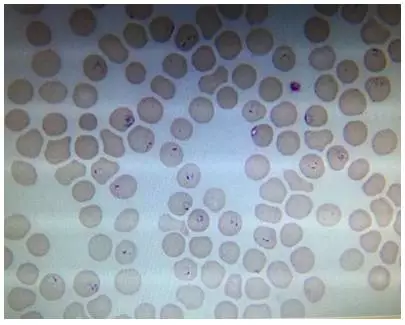
123123 8e250

病例:
患者,54岁中年男性,澳大利亚国籍,因腹泻6天加重伴头晕1天入院。半个月前曾前往尼日利亚出差,肾病病史。入院时患者神志清,呼吸急促,心率103次/分,血压74/40mmHg,SO2 98%,呼吸38次/分,四肢厥冷。入院诊断:考虑感染性休克。
血常规检查结果显示:白细胞(WBC) 6.81×10^9/L,以中性粒细胞(NEUT)为主占70.1%,淋巴细胞(LYMPH)19.6%,单核细胞(MONO) 5.7%,血红蛋白(HGB) 155g/L,红细胞计数 5.17×10^12/L,血小板数量明显降低(PLT)20x10^9/L,触发复检规则:小于60x10^9/L血小板减少的初诊病人需要用光学法复查。复查结果显示血小板仍然低于PLT 21x10^9/L,但是同时得到的网织红细胞计数结果显示其值明显增高为0.2776×10^12/L,网织红细胞千分率高达53.7%,由于这个病人并不贫血,所以这么高的网织红细胞计数引起了工作人员的注意,所以对该标本进行人工镜检了解初步情况,结果发现血涂片上 大量成熟红细胞内有疟原虫环状体,部分细胞胞内可见2个甚至3个,计数被感染的红细胞比率大概在百分之五十左右。
分析:
大量疟原虫环状体感染成熟红细胞后存在于红细胞内,导致细胞内的RNA数量增大,而仪器在进行网织红细胞计数时,荧光染料会把这些疟原虫环状体RNA也同样进行染色测定,导致测定结果比正常值要大,感染的红细胞越多那么这个值也越大。这个就是今天这个病人网织红细胞假性增高的原因。但是疟原虫感染不一定只引起网织红细胞增高,也有报道可能引起嗜酸性粒细胞假性增高,这种情况见于疟原虫的滋养体、裂殖体或配殖体增多时的情况。这种情况下,他们认为疟原虫消化血红蛋白产生疟色素从感染的血细胞中释放出来,继而被中性粒细胞吞噬从而导致在测定这类细胞时仪器出现偏差,误认为是嗜酸性粒细胞增高,但是上述情况我们在散点图上可以和正常细胞进行比较区别,从而发现问题。
(内容来源于华西实验医学网,转载出于传递更多信息之目的,版权和荣誉归原作者所有。如有侵权请联系我们妥善处理!)


